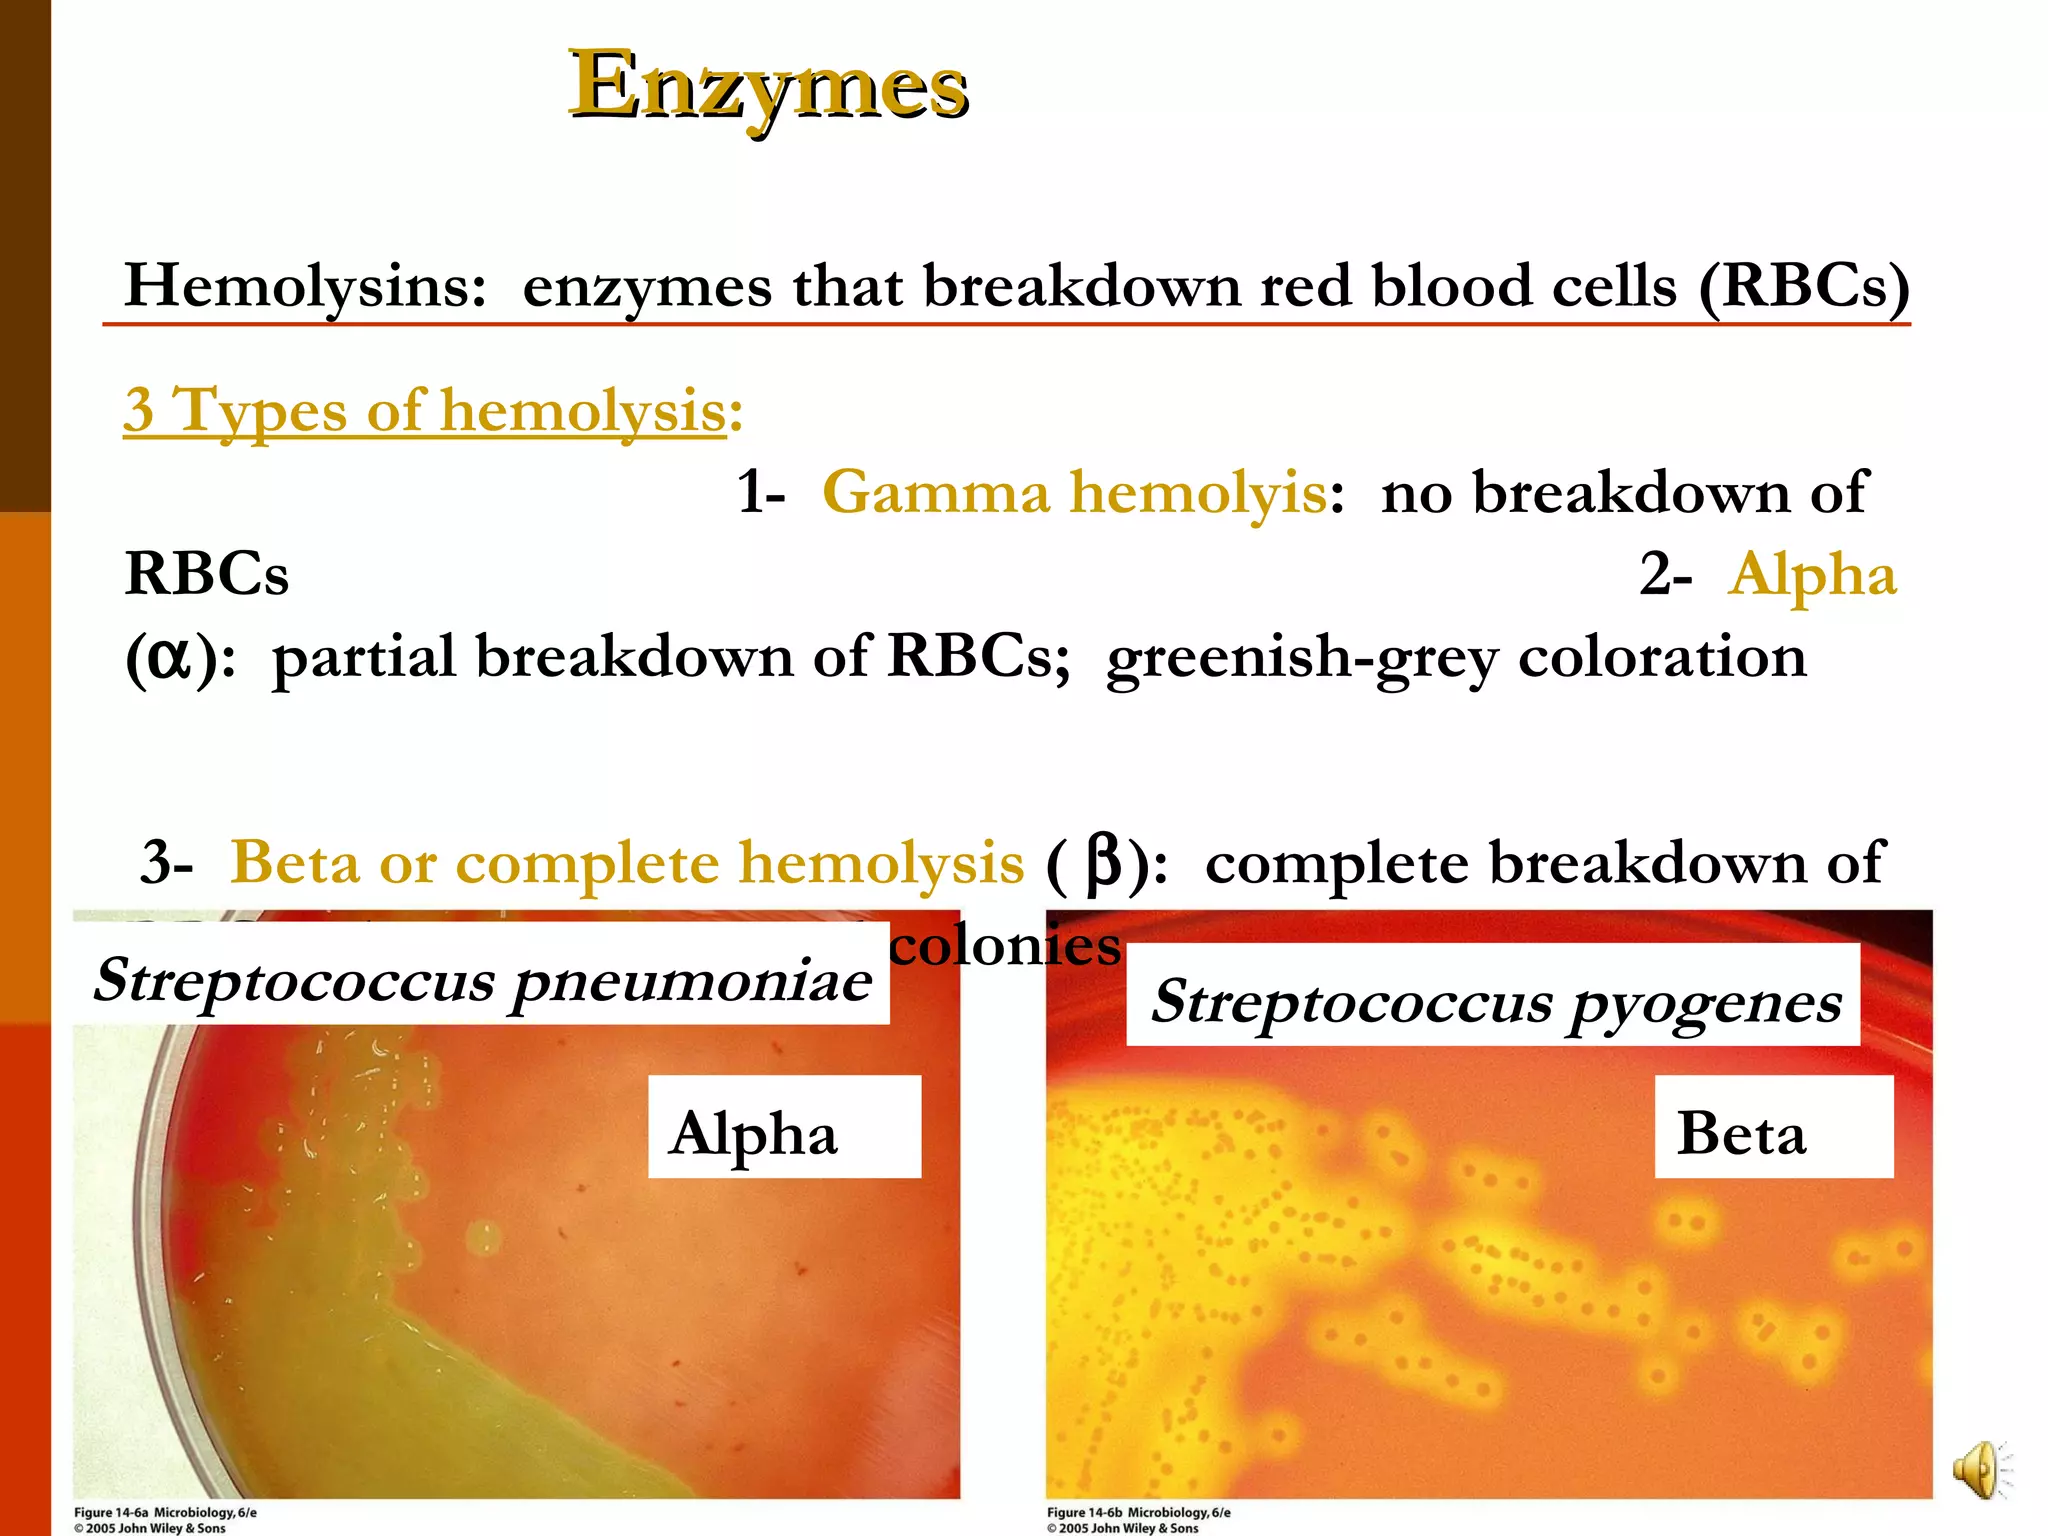

This document provides an overview of key concepts in microbiology including host-microbe relationships, types of infectious diseases, modes of disease transmission, and factors that affect disease establishment. It defines important terms like pathogens, hosts, symbiosis, and discusses examples of mutualism and parasitism. It also summarizes the stages of infectious diseases, types of infectious diseases, and how epidemiology studies the frequency and spread of diseases.